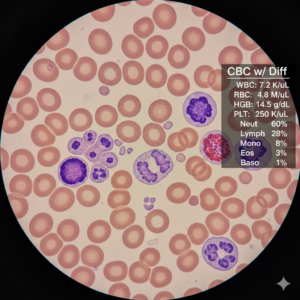
CBC with Differential

C-Reactive Protein
$51.00A general marker of inflammation in the body. Useful for assessing risk of cardiovascular disease and overall systemic stress.
Showing 17–32 of 86 results

A general marker of inflammation in the body. Useful for assessing risk of cardiovascular disease and overall systemic stress.

Measures the immune system’s IgG response to Candida yeast. Used to assess chronic yeast overgrowth or systemic candidiasis.
Complete Blood Count. A foundational health check that analyzes red and white blood cells and platelets, useful for screening for infection or anemia.

Measures antibodies (usually IgA/IgG) related to gluten consumption. Used as an initial screen for Celiac disease and gluten sensitivity.

A comprehensive panel measuring various antibodies (tTG, DGP, IgA/IgG) used to aid in the diagnosis of Celiac disease and gluten sensitivity.

Advanced muscle and tissue damage profile measuring Creatine Kinase and Lactate Dehydrogenase isoenzymes, used for organ-specific assessment.

A 14-test panel covering kidney and liver function, electrolytes, blood glucose, and protein levels. Provides a broad snapshot of your body chemistry.

Measures levels of this trace mineral critical for energy production, iron metabolism, and connective tissue formation.

Measures the primary stress hormone in the morning. Used to evaluate adrenal function and the body’s response to chronic stress.

Measures the total amount of this enzyme, which can indicate muscle damage or stress in skeletal or cardiac tissue.

Measures a protein fragment released when a blood clot dissolves. Used to screen for the presence of abnormal clotting activity.

DHEA-S. A precursor hormone produced primarily by the adrenal glands. Used to assess adrenal health, stress response, and sex hormone production.

Dihydrotestosterone (DHT). Measures the most potent form of testosterone. Key for investigating hair loss, prostate health, and androgen status.

Measures antibodies to EBV. Used to diagnose current, past, or reactivated infections of the virus linked to mononucleosis.

Erythrocyte Sedimentation Rate. A non-specific test for inflammation that measures how quickly red blood cells settle in a test tube.

The most potent form of estrogen. Measured to assess reproductive, bone, and heart health in women, and hormonal balance in men.
End of content
End of content
Notifications